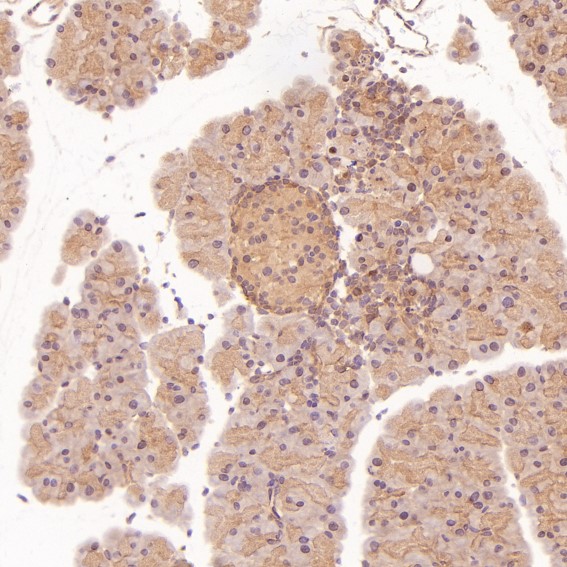
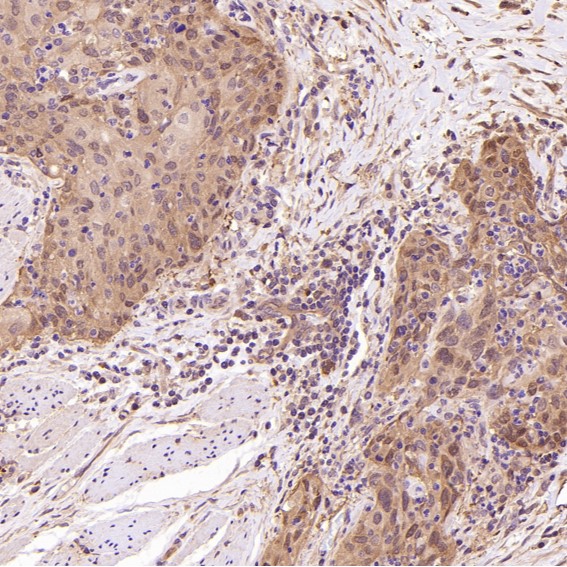
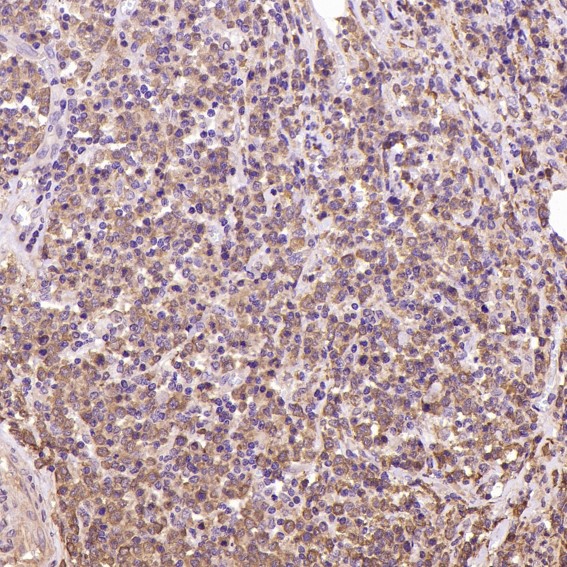

单克隆抗体
Hsp90 Antibody (CY5548)
UniProt:P07900/P08238
Application:WB,IHC,ICC/IF,IP,FC
Reactivity:Human,Mouse,Rat
Source:Rabbit mAb
Hsp90 Antibody (CY5548)
UniProt:P07900/P08238
Application:WB,IHC,ICC/IF,IP,FC
Reactivity:Human,Mouse,Rat
Source:Rabbit mAb
http://www.abways.cn/showproduct.asp?cid=CY5548
KRAS+HRAS+NRAS Antibody (CY5549)
References (1)
UniProt:P01111/P01112/P01116
Application:WB,ICC/IF,IP,FC
Reactivity:Human,Mouse,Rat
Source:Rabbit mAb
KRAS+HRAS+NRAS Antibody (CY5549)
UniProt:P01111/P01112/P01116
Application:WB,ICC/IF,IP,FC
Reactivity:Human,Mouse,Rat
Source:Rabbit mAb
References(1)
http://www.abways.cn/showproduct.asp?cid=CY5549
Histone H3.3 Antibody (CY5550)
UniProt:P84243
Application:WB,IHC,ICC/IF
Reactivity:Human,Mouse,Rat
Source:Rabbit mAb
Histone H3.3 Antibody (CY5550)
UniProt:P84243
Application:WB,IHC,ICC/IF
Reactivity:Human,Mouse,Rat
Source:Rabbit mAb
http://www.abways.cn/showproduct.asp?cid=CY5550
AKT1 Antibody (CY5551)
References (2)
UniProt:P31749
Application:WB,IHC,ICC/IF,IP,FC
Reactivity:Human,Mouse,Rat
Source:Rabbit mAb
AKT1 Antibody (CY5551)
UniProt:P31749
Application:WB,IHC,ICC/IF,IP,FC
Reactivity:Human,Mouse,Rat
Source:Rabbit mAb
References(2)
http://www.abways.cn/showproduct.asp?cid=CY5551
GRM5 Antibody (CY5552)
UniProt:P41594
Application:WB,IHC,ICC/IF,FC
Reactivity:Human,Mouse,Rat
Source:Rabbit mAb
GRM5 Antibody (CY5552)
UniProt:P41594
Application:WB,IHC,ICC/IF,FC
Reactivity:Human,Mouse,Rat
Source:Rabbit mAb
http://www.abways.cn/showproduct.asp?cid=CY5552

销售咨询
一键电话